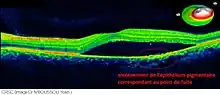
CRSC coupe OCT

Choriorétinopathie séreuse centrale
La choriorétinopathie séreuse centrale (CRSC) est une affection rétinienne entrainant des troubles de la vision, dont la lésion la plus caractéristique est le décollement séreux rétinien (DSR), une infiltration de liquide entre l'épithélium pigmentaire et les couches supérieures de la rétine[1].
Introduction
La CRSC est une affection oculaire uni ou bilatérale pouvant occasionner des troubles de la vision. Elle est caractérisée par un décollement séreux aigu de la neurorétine (DSR), lié à une zone de passage de liquide de la choroïde vers l'espace sous-rétinien. [2]
Il semblerait que la choroïde soit le siège d'une vasodilatation et d'une hyperperméabilité entraînant son épaississement non seulement sur l'œil atteint mais également sur l'œil controlatéral, suggérant une choroïdopathie sous-jacente à la maladie.
La CRSC est une maladie qui touche plus fréquemment les hommes d'âge moyen et est provoquée et/ou aggravée par la corticothérapie. Dans la majorité des cas, l’issue est favorable et le décollement séreux rétinien se réapplique de façon spontanée sans aucun traitement.
Les récidives, la bilatérisation et/ou le passage à la chronicité conduiraient à l’Epithéliopathie rétinienne diffuse, forme beaucoup plus sévère de la maladie, pouvant conduire à une altération permanente de la fonction visuelle. De multiples traitements ont été proposés : le laser d'un point de fuite extra fovéolaire et la photothérapie dynamique à fluence complète ou demi-fluence sont les modalités thérapeutiques dont l'efficacité a été démontrée. D'autres traitements médicamenteux sont à l'étude et méritent validation[3].
Découverte
La maladie a été initialement décrite par Albrecht von Gräfe en 1866, caractérisée par Alfred Edward Maumenee (en), puis par John Donald MacIntyre Gass (en). En 1987, le Dr Lawrence Yannuzzi (en) a établi un lien entre la CRSC et la personnalité de type A[4].
Epidémiologie

La CRSC atteint plus fréquemment les hommes d'âge moyen. l'exposition récente à un stress et une personnalité de type A (caractérisée par un surinvestissement professionnel et une forte exigence de soi) sont les facteurs de risque les plus reconnus de CRSC, mais d'autres facteurs favorisants sont progressivement identifiés.
De nombreuses CRSC sont probablement non diagnostiquées car asymptomatique quand le DSR est situé en région extrafovéolaire.
On estime que la CRSC est la quatrième maladie rétinienne en termes de fréquence, après la dégénérescence maculaire liée à l'âge (DMLA), la rétinopathie diabétique et l'occlusion de branche de veine rétinienne[5].
Chez la femme, la maladie survient a un âge plus tardif (entre 40 et 55 ans )[6].
Chez les patients de plus de 60 ans, le diagnostic différentiel avec une DMLA est parfois délicat.
Facteur de risque
- La corticothérapie (intranasale, inhalée, topique, intra-articulaire, etc.) ou générale (orale ou intraveineuse)[7]
- La Personnalité de type A[4]
- La maladie de Cushing[8]
- La grossesse (3e trimestre)[9]
- l'Hypertension artérielle[10]
Clinique
La symptomatologie est variable d’un patient à l’autre, allant de cas asymptomatique à une baisse permanente de l’acuité visuelle
Quand elle est symptomatique, la CRSC se manifeste le plus souvent par un syndrome maculaire sur un œil blanc et indolore. Les différents symptômes que l’on retrouve sont :
- Une baisse de vision
- un scotome central ou paracentral relatif (surtout matinal)
- des métamorphopsies,
- des dyschromatopsies,
- des micropsies
- une diminution de la sensibilité aux contrastes est fréquemment retrouvée[18].
Dans les formes aiguës, l'acuité visuelle est en général peu altérée (oscillant entre 7 et 10/10). Elle est améliorée après la correction d'une hypermétropie de une à trois dioptries, en raison du déplacement antérieur de la neurorétine fovéolaire 3. Dans les formes chroniques, la vision peut être profondément diminuée de façon permanente (1/10 ou moins).
Examen clinique
À l'examen l’œil est blanc, non inflammatoire et non douloureux. Le fond d’œil montre un soulèvement maculaire, une bulle qui peut être plus ou moins étendue (de 1 à 3 diamètres papillaires). Si elle est minime, il faudra un examen très attentif pour la déceler. On note parfois des points jaune chamois entre le neuro-épithélium et l'épithélium pigmenté.
Il ne doit pas y avoir d'hémorragie à ce niveau. Si tel est le cas, il faut s'orienter vers un autre diagnostic.
Angiographie
L'angiographie était un examen essentiel dans le diagnostic et la surveillance d'une CRSC. Aujourd'hui on lui préfère l'OCT pour sa rapidité d'exécution et son côté non invasif.
L'angiographie reste cependant utile pour localiser le point de fuite lorsqu'un traitement par photocoagulation au laser est envisagé.
Lors de l'examen, La séquence sera assez longue, avec des clichés précoces et des clichés tardifs.
En vert on voit bien la bulle claire de DSNE, précisée par la rupture du parallélisme des lignes de profil antérieure et postérieure.
À 15 secondes après injection de la fluorescéine, on se rend compte d'un point hyperfluorescent près de la fovéa apparaissant dès le temps artério-veineux. La visibilité anormalement bonne des capillaires rétiniens centraux est due à la saillie de la bulle rétinienne qui ne fait que très peu effet masque. Son contenu est en effet transparent.
À 60 secondes, on assiste à une importante diffusion du colorant autour du point de fuite. C'est la forme classique en « tache d'encre » ou de « phare dans le brouillard ». On obtient parfois une image en « jet de vapeur » ou en « plumeau ».
À 500 secondes, l'ensemble de la bulle soulevée est coloré par l'accumulation du colorant issu du point de fuite. La fluorescence ne déborde jamais des limites de la bulle.
On s'attachera à rechercher des fuites sur l'ensemble de la rétine, car un point de fuite loin de la macula peut passer inaperçu.
L'angiographie au vert d'indocyanine (ICG) mettra en évidence l'une des zones de choroïde hyperfluorescentes là où on observe les points de fuite du colorant. Cet examen n'est pas souvent nécessaire dans l'étude de la maladie.
Tomographie en cohérence optique (TCO)

La tomographie en cohérence optique est un examen récent qui permet de réaliser une coupe quasi histologique de la rétine et de suivre l'évolution de la bulle maculaire. Son innocuité et sa facilité d'utilisation en feront sans doute un élément important de l'exploration des CRSC.
Diagnostic différentiel
La CRSC peut être confondue avec :
- une fossette colobomateuse de la papille. Le DSNE est de siège intermaculopapillaire et il n'y a pas de point de fuite à l'angiographie.
- des néovaisseaux sous-rétiniens. L'importante baisse de vision et des différences fines visibles sur les clichés angiographiques doivent permettre le diagnostic.
- une uvéite postérieure de Vogt Koyanagi Harada. Une papillite s'ajoute aux signes angiographiques bruyants.
- les tumeurs, une effusion uvéale, une coagulation intravasculaire disséminée, une ischémie choroïdienne multifocale, un disque vitelliforme débutant.
Il faut bien regarder les clichés car certaines angiographies sont difficiles à interpréter. Le Dr Park résume le problème : « When diagnosing CSCR, the devil is often in the details » (Quand on essaye de faire le diagnostic d'une CRSC, le diable est souvent dans les détails).[réf. nécessaire]
Évolution et traitement
L'évolution spontanée se fera en principe (90 % des cas) vers une guérison spontanée, sans traitement. On peut parfois prescrire des collyres anti-inflammatoires. Il faut compter trois à quatre mois pour la résorption de la bulle et l'amélioration de la vision.
Une récidive est possible, quelques mois ou quelques années plus tard (30 % des cas).
Dans certains cas on est amené à réaliser une photocoagulation laser pour fermer la fuite. On applique 3 à 5 impacts de 200µm, d'une durée de 0,1 seconde. En fonction de l'angiographie on va adapter le traitement si nécessaire.
On ne sait pas si ce traitement raccourcit vraiment l'évolution de la CRSC et si l'évolution spontanée n'aurait pas fait aussi bien. C'est l'ophtalmologiste qui dira si un laser est envisageable en fonction des angiographies et de la clinique. La décision n'est pas toujours simple à prendre.
Un élément important du traitement est la prise en charge psychologique, ce qui permettra souvent d'accélerer la guérison et la vision.
Quelques patients ne guérissent pas bien et présentent une baisse de vision définitive, avec un aspect angiographique de diffusion permanente.
Le risque de complication, de néovascularisation sous-rétinienne est faible mais semble plus fréquent chez les patients les plus âgés. Ces patients sont souvent hypertendus et soumis à une corticothérapie.
Références
- ↑ 1; Maalej, A. Khallouli, C. Wathek, R. Rannen et S. Gabsi, « La choriorétinopathie séreuse centrale: corrélations anatomo-cliniques », Journal français d'ophtalmologie, vol. 37, no 10, (ISSN 0181-5512, lire en ligne, consulté le )
- ↑ Elsevier Masson, « Choriorétinite séreuse centrale », sur EM-Consulte (consulté le )
- ↑ (en) « Central Serous Chorioretinopathy - EyeWiki », sur eyewiki.aao.org (consulté le )
- 1 2 L. A. Yannuzzi, « Type-A behavior and central serous chorioretinopathy », Retina (Philadelphia, Pa.), vol. 7, no 2, , p. 111–131 (ISSN 0275-004X, PMID 3306853, lire en ligne, consulté le )
- ↑ Maria Wang, Inger Christine Munch, Pascal W. Hasler et Christian Prünte, « Central serous chorioretinopathy », Acta Ophthalmologica, vol. 86, no 2, , p. 126–145 (ISSN 1755-3768, PMID 17662099, DOI 10.1111/j.1600-0420.2007.00889.x, lire en ligne, consulté le )
- ↑ Godfrey Quin, Gerald Liew, I.-Van Ho et Mark Gillies, « Diagnosis and interventions for central serous chorioretinopathy: review and update », Clinical & Experimental Ophthalmology, vol. 41, no 2, , p. 187–200 (ISSN 1442-9071, PMID 22788713, DOI 10.1111/j.1442-9071.2012.02847.x, lire en ligne, consulté le )
- ↑ Evrydiki A. Bouzas, Panagiotis Karadimas et Constantin J. Pournaras, « Central serous chorioretinopathy and glucocorticoids », Survey of Ophthalmology, vol. 47, no 5, , p. 431–448 (ISSN 0039-6257, PMID 12431693, lire en ligne, consulté le )
- ↑ E. A. Bouzas, M. H. Scott, G. Mastorakos et G. P. Chrousos, « Central serous chorioretinopathy in endogenous hypercortisolism », Archives of Ophthalmology (Chicago, Ill.: 1960), vol. 111, no 9, , p. 1229–1233 (ISSN 0003-9950, PMID 8363466, lire en ligne, consulté le )
- ↑ J. D. Gass, « Central serous chorioretinopathy and white subretinal exudation during pregnancy », Archives of Ophthalmology (Chicago, Ill.: 1960), vol. 109, no 5, , p. 677–681 (ISSN 0003-9950, PMID 2025170, lire en ligne, consulté le )
- ↑ M. K. Tittl, R. F. Spaide, D. Wong et E. Pilotto, « Systemic findings associated with central serous chorioretinopathy », American Journal of Ophthalmology, vol. 128, no 1, , p. 63–68 (ISSN 0002-9394, PMID 10482095, lire en ligne, consulté le )
- ↑ Robert Haimovici, Shimon Rumelt et James Melby, « Endocrine abnormalities in patients with central serous chorioretinopathy », Ophthalmology, vol. 110, no 4, , p. 698–703 (ISSN 0161-6420, PMID 12689888, DOI 10.1016/S0161-6420(02)01975-9, lire en ligne, consulté le )
- ↑ K. Aliferis, I. K. Petropoulos, B. Farpour et M. A. Matter, « Should central serous chorioretinopathy be added to the list of ocular side effects of phosphodiesterase 5 inhibitors? », Ophthalmologica. Journal International D'ophtalmologie. International Journal of Ophthalmology. Zeitschrift Fur Augenheilkunde, vol. 227, no 2, , p. 85–89 (ISSN 1423-0267, PMID 22156704, DOI 10.1159/000333824, lire en ligne, consulté le )
- ↑ Elif Damar, Yasin Toklu, Altug Tuncel et Melih Balci, « Does therapeutic dose of sildenafil citrate treatment lead to central serous chorioretinopathy in patients with erectile dysfunction? », American Journal of Men's Health, vol. 7, no 5, , p. 439–443 (ISSN 1557-9891, PMID 23479433, DOI 10.1177/1557988313480808, lire en ligne, consulté le )
- ↑ Patrik Kloos, Irene Laube et Adelheid Thoelen, « Obstructive sleep apnea in patients with central serous chorioretinopathy », Graefe's Archive for Clinical and Experimental Ophthalmology = Albrecht Von Graefes Archiv Fur Klinische Und Experimentelle Ophthalmologie, vol. 246, no 9, , p. 1225–1228 (ISSN 0721-832X, PMID 18546012, DOI 10.1007/s00417-008-0837-0, lire en ligne, consulté le )
- ↑ M. Mauget-Faÿsse, L. Kodjikian, M. Quaranta et D. Ben Ezra, « [Helicobacter pylori in central serous chorioretinopathy and diffuse retinal epitheliopathy. Results of the first prospective pilot study] », Journal Francais D'ophtalmologie, vol. 25, no 10, , p. 1021–1025 (ISSN 0181-5512, PMID 12527825, lire en ligne, consulté le )
- ↑ Marta Misiuk-Hojło, Magdalena Michałowska et Anna Turno-Krecicka, « Helicobacter pylori--a risk factor for the developement of the central serous chorioretinopathy », Klinika Oczna, vol. 111, nos 1-3, , p. 30–32 (ISSN 0023-2157, PMID 19517842, lire en ligne, consulté le )
- ↑ J. A. Oosterhuis, « Familial central serous retinopathy », Graefe's Archive for Clinical and Experimental Ophthalmology = Albrecht Von Graefes Archiv Fur Klinische Und Experimentelle Ophthalmologie, vol. 234, no 5, , p. 337–341 (ISSN 0721-832X, PMID 8740256, lire en ligne, consulté le )
- ↑ Maria Wang, Inger Christine Munch, Pascal W. Hasler et Christian Prünte, « Central serous chorioretinopathy », Acta Ophthalmologica, vol. 86, no 2, , p. 126–145 (ISSN 1755-3768, PMID 17662099, DOI 10.1111/j.1600-0420.2007.00889.x, lire en ligne, consulté le )
Liens externes
Bibliographie
- Portail de la médecine